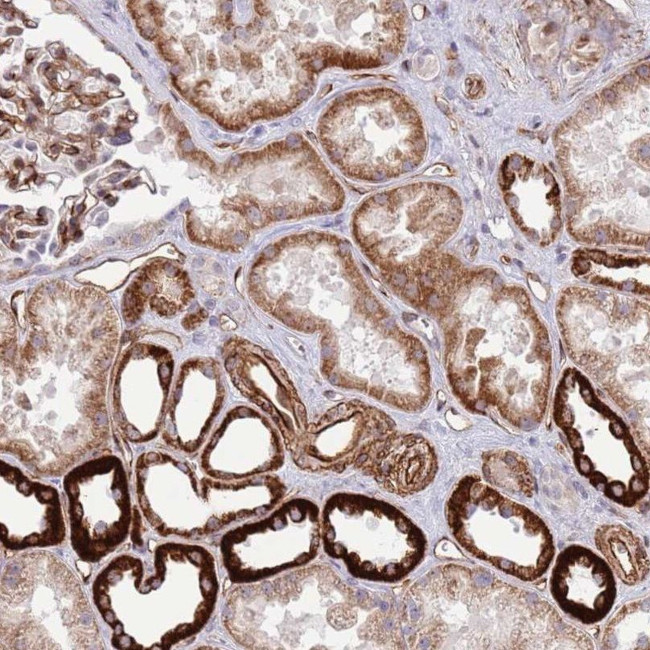
NEK3 Antibody in Immunohistochemistry (IHC)

Search
Invitrogen
NEK3 Polyclonal Antibody
{{$productOrderCtrl.translations['antibody.pdp.commerceCard.promotion.promotions']}}
{{$productOrderCtrl.translations['antibody.pdp.commerceCard.promotion.viewpromo']}}
{{$productOrderCtrl.translations['antibody.pdp.commerceCard.promotion.promocode']}}: {{promo.promoCode}} {{promo.promoTitle}} {{promo.promoDescription}}. {{$productOrderCtrl.translations['antibody.pdp.commerceCard.promotion.learnmore']}}
产品信息
PA5-53911
种属反应
宿主/亚型
分类
类型
抗原
偶联物
形式
浓度
规格
纯化类型
保存液
内含物
保存条件
运输条件
RRID
产品详细信息
Immunogen sequence: NLILKVCQGC ISPLPSHYSY ELQFLVKQMF KRNPSHRPSA TTLLSRGIVA RLVQKCLPPE IIMEYGEEVL EEIKNSKHNT PRKKTNPSRI RIALGNEAST V
Highest antigen sequence identity to the following orthologs: Mouse - 64%, Rat - 60%.
靶标信息
NIMA was originally shown in Aspergillus nidulans to be necessary for entry into mitosis. NIMA-related mammalian proteins have since been identified as Nek1, Nek2, Nek3 and Nek4 (also designated STK2 or NRK2). High expression of Nek1 is seen in male and female germ cell lines of mouse. Nek2 is the closest known mammalian relative to NIMA. Like NIMA, Nek2 expression peaks at the G2 to M phase transition. Nek3 is a predominantly cytoplasmic enzyme that was detectable in all organs studied. Levels of Nek3 seem to remain unchanged throughout the cell cycle, but appear to be elevated in G0-arrested, quiescent fibroblasts. In developing testicular germ cells, differential patterns of expression were seen for Nek1, Nek2 and Nek4, indicating possible overlapping, but non-identical functions.
仅用于科研。不用于诊断过程。未经明确授权不得转售。
篇参考文献 (0)
生物信息学
蛋白别名: glycogen synthase A kinase; HSPK 36; hydroxyalkyl-protein kinase; Never in mitosis A-related kinase 3; NIMA (never in mitosis gene a)-related kinase 3; NimA-related protein kinase 3; phosphorylase B kinase kinase; Serine/threonine-protein kinase Nek3; unnamed protein product
基因别名: HSPK36; NEK3
UniProt ID: (Human) P51956
Entrez Gene ID: (Human) 4752